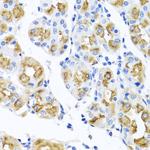
FECH Antibody in Immunohistochemistry (Paraffin) (IHC (P))

Search
Invitrogen
FECH Polyclonal Antibody
{{$productOrderCtrl.translations['antibody.pdp.commerceCard.promotion.promotions']}}
{{$productOrderCtrl.translations['antibody.pdp.commerceCard.promotion.viewpromo']}}
{{$productOrderCtrl.translations['antibody.pdp.commerceCard.promotion.promocode']}}: {{promo.promoCode}} {{promo.promoTitle}} {{promo.promoDescription}}. {{$productOrderCtrl.translations['antibody.pdp.commerceCard.promotion.learnmore']}}
图: 1 / 5
FECH Antibody (PA5-97044) in IHC (P)

Please note: We are reviewing Western blot images included in the antibody testing data in our catalog, including those provided by third parties. Unless expressly labeled or annotated as “raw-unedited”, Western blot images included in the antibody testing data in our catalog may have been edited, optimized or otherwise adjusted for presentation.
产品信息
PA5-97044
种属反应
宿主/亚型
分类
类型
抗原
偶联物
形式
浓度
规格
纯化类型
保存液
内含物
保存条件
运输条件
RRID
产品详细信息
Immunogen sequence: MRSLGANMAA ALRAAGVLLR DPLASSSWRV CQPWRWKSGA AAAAVTTETA QHAQGAKPQV QPQKRKPKTG ILMLNMGGPE TLGDVHDFLL RLFLDRDLMT LPIQNKLAPF IAKRRTPKIQ EQYRRIGGGS PIKIWTSKQG EGMVKLLDEL SPNTAPHKYY IGFRYVHPLT EEAIEEMERD GLERAIAFTQ YPQYSCSTTG; Positive Samples: HepG2, HT-29, Mouse brain; Cellular Location: Matrix side, Mitochondrion inner membrane, Peripheral membrane protein
靶标信息
The protein encoded by this gene is localized to the mitochondrion, where it catalyzes the insertion of the ferrous form of iron into protoporphyrin IX in the heme synthesis pathway. Mutations in this gene are associated with erythropoietic protoporphyria. Two transcript variants encoding different isoforms have been found for this gene. A pseudogene of this gene is found on chromosome 3.
仅用于科研。不用于诊断过程。未经明确授权不得转售。
篇参考文献 (0)
生物信息学
蛋白别名: Ferrochelatase, mitochondrial; Heme synthase; heme synthetase; Protoheme ferro-lyase; protoporphyria; protoporphyrin ferrochelatase; unnamed protein product
基因别名: AI894116; EPP; EPP1; FCE; fch; Fcl; FECH
UniProt ID: (Mouse) P22315
Entrez Gene ID: (Human) 2235, (Rat) 361338, (Mouse) 14151




